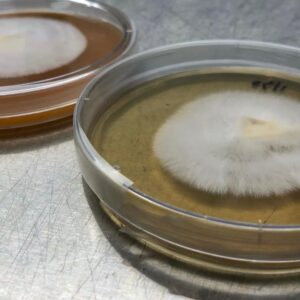

İhtiyacınız olan her şey, tabağınızda.
Mucizevi besinlerden siz de yararlanın
Yemek listenize birkaç lezzetli mantar porsiyonu ekleyerek bir dizi hastalıkla savaşabilir, sağlıklı ve uzun bir yaşamın kapısını aralayabilirsiniz. Şunu unutmamak gerekir, yüzyıllardır bir çok yararlı antibiyotiğin üretiminde mantarlar kullanılmıştır.
Ergothioneine ve Glutathione gibi antioksidanlar açısından zengin olan mantarlar, hücreleri serbest radikallerden korur ve vücudun sağlıklı hücrelere zarar veren normal oksidatif strese karşı korunmasına yardımcı olur. Probiyotik özellikleri sayesinde mikrobiyomun Acidophilus ve Bifidobacterium gibi yararlı bakterilerini artırarak sindirimi ve genel sağlığı iyileştirir.

Bu Mantarlar Fransız Şeflerin Hayali!
Dünya üzerinde 5,1 milyon mantar türü bulunmaktadır, fakat hepsini birden yemek istemezsiniz. En iyilerini topladık ve araştırmalarımız sonucu 20 yıldır üretiyoruz ve geliştiriyoruz.
Naturel Form

Geleneksel yöntemlerle kurutulan mantarlar başka bir işlem görmeden naturel yapıda paketlenir.
Dilimlenmiş Form

Kolay kullanabilmeniz için sizi düşünerek kurutup, dilimliyoruz.
Öğütülmüş Form

Yemeklere aroma katmak ve hemen mantar çayını hazırlamak isteyenlere.
Leziz yemekler için taze mantarlar!
Etin yanına, makarnanın üzerine veya direkt tavaya. Özellikle Shiitake, Eryngi ve Yaprak Mantarı türlerini günlük toplayıp mutfağınıza en taze şekilde gönderiyoruz.

Çin ve Japon tıbbından tüm dünyaya
Uzakdoğu ve Avrupa’da yüksek olan mantar tüketim oranı, ülkemizde de giderek artmaktadır.
Yenebilir mantarlar genel olarak, düşük kalori, yağ ve şeker içeriğinin yanında, yüksek B Vitamini, D Vitamini, Selenyum, Demir ve Antioksidanlar içermektedir.
İçeceğiniz En Sağlıklı Çay
Özellikle Reishi ve Koriolus gibi sert yapılı mantarların tüm içeriğini alabilmek için kaynatın ve çayınızı hazırlayın.

Türkiye’nin Her Bölgesine Hızlı Gönderi
Ürünlerimizi özenle paketleyip 1 gün içerisinde kargoya teslim ediyoruz.

En Doğal Haliyle Üretiyoruz

Hijyenik ve modern işletmemizde Shiitake ve diğer tıbbi mantar türlerinin üretimi ve araştırması yapılmaktadır.

4 Basit Adımda Mantarlarınızı
Toplamaya Başlayın
Kes >> Yerleştir >> Sula >> Topla

Sarı İstiridye Mantarı Üretim Kiti

Pembe İstiridye Mantarı Üretim Kiti

Gri İstiridye Mantarı Üretim Kiti
Mantarlarınızı
Toplamaya Başlayın
Ortamı Hazırla >> Ek >> Yerleştir >> Sula >> Topla

Sarı İstiridye Mantarı miseli (TOHUM)

Pembe İstiridye Mantarı miseli (TOHUM)

Gri İstiridye Mantarı
miseli (TOHUM)
İşi Uzmanına Sorun.
40 yıllık mantar üretim tecrübesi ile ülkemizde dünyanın en değerli mantarlarını sizler için üretiyoruz.

Ürünlerinizi hemen hazırlıyoruz, online olarak alın!
Taze olduğu ve koruyucu içermediği için stokları kontrol etmeyi unutmayın.
Biz Neredeyiz?
Tüm bunları nerede yapıyoruz?
Ücretsiz Kargo
150 TL ve üzeri alışverişinizde kargo ücretsiz.






